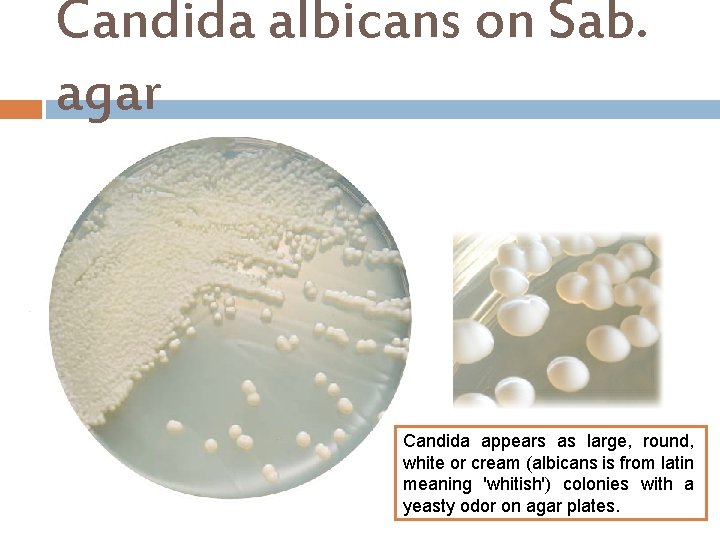
Candida albicans on Sab. agar Candida appears as large, round, white or cream (albicans

VAGINAL DISCHARGE CULTURE Specimen processing for Vaginal swab

VAGINAL DISCHARGE CULTURE

Specimen processing for Vaginal swab

Vaginitis Inflammation of the vaginal mucosa called vaginitis. Women who present with vaginal symptoms often complain of an abnormal discharge and possibly other symptoms such as offensive odor and itching. The three most common cause of vaginitis in premenopausal women are vaginal candidiasis, bacterial vaginosis and trichomoniasis. Bacterial vaginosis BV is caused by an imbalance of naturally occurring bacterial flora of vagina.

Bacterial Vaginosis Non-cultural diagnosis can be made by detection at least three of the following four characteristics: I. Thin, homogeneous discharge adhering to the vaginal wall. II. p. H greater than 4. 5. III. Fishy odor intensified on addition of 10% potassium hydroxide. IV. Presence of clue cells by microscopic examination of the discharge.

Bacterial Vaginosis A Whiff test Several drops of 10 % a potassium hydroxide (KOH) solution may also be added to a sample of the vaginal discharge to test for any resultant strong fishy (amine) odor from the mix, which would indicate bacterial vaginosis. p. H measuring by using litmus papers, Normal vaginal p. H is between 3. 8 -4. 5 p. H.

Bacterial Vaginosis

Bacterial Vaginosis At least 10– 20 high power (1000× oil immersion) fields are counted an average determined.

Clue cells are vaginal squamous epithelial cells coated with coccobacilli gram variable Gardnerella vaginalis adhering to their surface and sometimes obscuring their borders. Clue cells indicate bacterial vaginosis. I. Mix a drop of vaginal fluid with a drop of saline on a glass slide. II. Place a coverslip over the suspension and examine the preparation microscopically at x 400 magnification. III. Clue cells are squamous epithelial cells covered with many small coccobacillary organisms , giving a stippled, granular aspect the edges of these epithelia cells are not clearly defined , owing to the large number of bacteria present.

Clue cells Wet mount

Clue cells Gram Stain

Normal Vaginal Gram Stain

Bacterial Vaginosis Garm Stain

Candidiasis or Candida Vaginitis Diagnosis is confirmed either by a simple wet mount, or better, a 10% potassium hydroxide wet mount microscopy and culture. Candida albicans is the major cause accounting for 85% of the isolates.

Wet mount and KOH smear KOH slide A sample of the vaginal discharge is placed on a slide and mixed with a solution of 10% potassium hydroxide (KOH). The KOH kills bacteria and cells from the vagina, leaving only yeast for easier detection of a yeast infection.

Sabouraud Dextrose agar Ingredients: I. Digest of casein. II. Digest of animal tissue. III. Dextrose. 4 % IV. Agar 1. 5 % Final p. H 5. 6 ± 0. 2 at 25°C Sabouraud Dextrose agar is used for the isolation, cultivation, and maintenance of saprophytic and pathogenic fungi. It supplies peptone as the protein source and dextrose as the carbohydrate source for nourishment. Bacterial suppression occur due to the low p. H (5. 6) p. H. Note: chloramphenicol may use to inhibit growth of bacteria.
Candida albicans on Sab. agar Candida appears as large, round, white or cream (albicans is from latin meaning 'whitish') colonies with a yeasty odor on agar plates.

Trichomoniasis or Trichomonas Vaginitis Trichomonas vaginalis
- Slides: 17